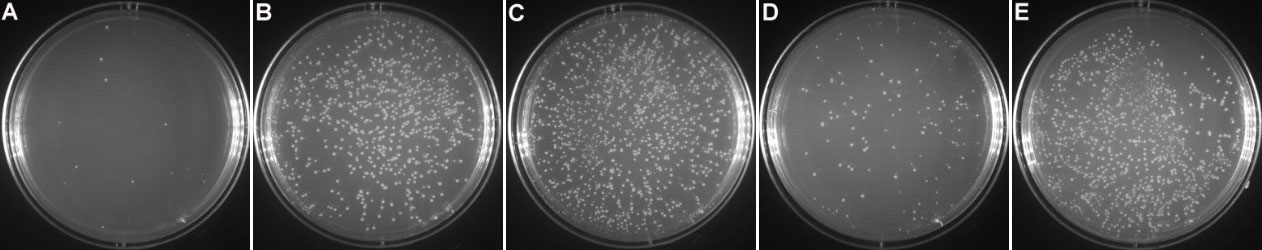
新闻图片16

微信扫一扫
关注公众号
- 特色产品 (13)
- 晶欣生物 (48)
- MBL (56)
- GRINER格瑞纳 (1091)
- 技术服务 (20)
- StemRD (75)
- Sciencell (1491)
- BIOMIGA (198)
- Genedirex (24)
- MD Bioproducts (140)
- Hemacare (226)
- Promocell (7158)
- ReproCELL (43)
- Stemgent (121)
- CUSABIO(武汉华美) (8986)
- Cohesion (11834)
- 科进KIRGEN (141)
- ibidi (256)
- Corning/康宁 (26)
- Cellvis (116)
- Thermo (46346)
- 润基生物 (86)
- 美仑 (3926)
- 普利莱 (2049)
- MPBIO (849)
- 瑞宁 (516)
- 赛百慷(iCell) (649)
- Bovogen (1)
- ZETA LIFE (1)
- Beckman/贝克曼 (524)
- biocoat (264)
- falcon (148)
- 爱萌优宁 (4483)
- 环凯生物 (947)
- Raybiotech (2396)
- SAB (37661)
- MCE (22947)
- 博士德 (23528)
- Alzet (4)
- Bio-rad/伯乐 (34)
- millipore/密理博 (49)
- Scigen (2)
- Leica/徕卡 (2)
- ZEISS/蔡司 (1)
- Cargille (1)
- Gibco (3)
- Wako (2533)
- VivaCell (228)
- 同仁化学 (474)
- 南京建成 (1894)
- GVS (715)
- Streck (2)
- 其他分类 (20)
碧云天促销活动,提供免费试用
发布时间:2017-02-07 15:02 | 点击次数:3196
GST标签蛋白纯化如此简单!
载量大、纯度高、兼容性好的超值GST柱!
免费试用装等您索取!
GST标签蛋白纯化,从此如此简单!
碧云天全新推出BeyoGold™ GST-tag Purification Resin!
俗称GST纯化介质、GST纯化柱或GST柱,
简单、快速、高效地纯化GST标签重组蛋白的纯化介质!
更提供配套齐全的纯化试剂盒,让GST纯化如此简单!
小量纯化、大量纯化都可以搞定!
离心、重力过柱和FPLC三种纯化方式均可!
GST pulldown、GST标签切除都可以兼容!
看看纯化效果吧(图1)!如果心动,赶快行动吧!可以免费试用,可以直接订购!

图1. GST标签蛋白纯化效果图。M:marker;CL:细菌裂解液(cell lysate);FT:上样流穿液(flow through);W1-W2:洗涤液1-2 (wash 1-2); E1-E5:洗脱液1-5 (elution 1-5)。注:实际的电泳结果会因样品、上样量等的不同而有所不同。
附产品订购信息:
| 产品编号 | 产品名称 | 包装 | 产品价格 |
| P2250 | BeyoGold™ GST-tag Purification Resin | 1ml | 56.00元 |
| P2251 | BeyoGold™ GST-tag Purification Resin | 10ml | 339.00元 |
| P2253 | BeyoGold™ GST-tag Purification Resin | 100ml | 2712.00元 |
| P2255 | BeyoGold™ GST-tag Purification Resin | 1000ml | 21680.00元 |
| P2262 | GST标签蛋白纯化试剂盒 | 10ml | 568.00元 |
离心柱式RNA纯化试剂盒,开启RNA抽提新时代!
和TRIzol说再见!长链RNA、小RNA和总RNA抽提全部玩转!
质量优于国际同类产品!低至6.8元每样!提供免费试用!
花开花落,辞旧迎新的季节
尽管是那么的不舍
为了诗和远方的田野,为了心中的碧云天
和TRIzol说再见!
忘却那熟悉的酚的味道
让离心柱式RNA纯化试剂盒与您安全相伴!
一起开启RNA抽提的新时代!!!
提供长链RNA、总RNA和小RNA三种RNA抽提试剂盒!彻底玩转RNA抽提!
为什么选择碧云天的RNAeasy™系列离心柱式RNA纯化试剂盒:
1. 使用安全。
通过特殊的柱纯化介质进行RNA分离纯化,能有效避免传统的Trizol法抽提时使用的酚等有毒有害有机试剂。
2. 超低价格,低至6.8元每样!比TRIzol抽提还省钱!小RNA抽提试剂盒性价比更高!
国内外同类离心柱式长链RNA或总RNA抽提产品价格通常在15-30元每样!TRIzol目前的报价为100ml 2422元,200ml 4363元。即使按照售价的6折计算,TRIzol的费用也要达到13元每样。需要特别注意的是,国外Qiagen等公司声称的总RNA抽提试剂盒其实是长链RNA抽提试剂盒,抽提产物中是不包含小RNA的。
碧云天的RNAeasy™动物小RNA抽提试剂盒(离心柱式)仅为12元每样,国内外同类产品价格通常在约45-125元每样!
3. 高质量,RNA纯度高、得率高!
RNA的纯度优于TRIzol和国际知名Q品牌RNA柱纯化试剂盒(参考图1);RNA得率接近TRIzol,显著优于国外同类产品(参考图1)。

图1. 碧云天RNAeasy™动物长链RNA抽提试剂盒(离心柱式)与Trizol、Q品牌同类产品的长链RNA抽提效果对比。样品为冻存的50万个HeLa细胞、20mg小鼠肝组织和20mg小鼠脑组织。洗脱液用量均为40μl。均取6μl洗脱的样品经变性处理后,在含6.67%甲醛和适量NA-Red的1.2%变性琼脂糖凝胶中电泳约45分钟后拍照。实际抽提效果会因实验条件、检测仪器等的不同而存在差异,本图仅供参考。图中可见碧云天的试剂盒在抽提肝组织和脑组织时的得率显著高于Q品牌的同类产品。图中A260/A230数据显示,碧云天试剂盒抽提肝组织或脑组织时,获得的RNA的纯度显著高于TRIzol法和Q品牌的同类产品。
注:纯的RNA其A260/A280约为2.0,但在很多仪器上测定时会高于2.0,低于1.9通常认为有蛋白、DNA或者酚等的污染;纯的RNA其A260/A230约为2.0左右或者略高,低于1.9通常认为有碳水化合物、胍盐、多肽或酚等的污染。
碧云天RNAeasy™动物小RNA抽提试剂盒(离心柱式)与国际知名T品牌小RNA抽提试剂盒的抽提效果对比图参见图2。图中可见,碧云天的试剂盒得率显著高于T品牌产品。

图2. 碧云天RNAeasy™动物小RNA抽提试剂盒(离心柱式)与T品牌同类产品的小RNA抽提效果对比。样品为冻存的100万个HeLa细胞、5mg小鼠肝组织和5mg小鼠肾组织。洗脱液用量均为30μl。均取6μl洗脱的样品经变性处理后,在含7M尿素的15% TBE-PAGE中电泳约90分钟后在NA-Red溶液中染色后拍照。碧云天试剂盒抽提产物的A260/A280依次为2.01、2.07和2.06;T品牌试剂盒抽提产物的A260/A280依次为1.93、1.79和1.29。实际抽提效果会因实验条件、检测仪器等的不同而存在差异,本图仅供参考。
碧云天的RNAeasy™动物总RNA抽提试剂盒(离心柱式)的抽提效果参见图3。图中可见,在28S RNA和18S RNA的比例明显大于2:1的同时,抽提获得了大量的小RNA。28S RNA和18S RNA的比例大于2:1,提示抽提出来的RNA完整性非常高,并说明抽提获得的小RNA并非RNA降解产生的。

图3. 碧云天的RNAeasy™动物总RNA抽提试剂盒(离心柱式)对于总RNA的抽提效果。样品为冻存的50万个HeLa细胞、5mg小鼠肝组织和5mg小鼠肾组织。洗脱液用量均为40μl。均取6μl洗脱的样品经变性处理后,在含6.67%甲醛和适量NA-Red的1.2%变性琼脂糖凝胶中电泳约45分钟后拍照。抽提产物的得率依次为9.6μg、8.5μg和4.1μg,A260/A280依次为2.11、2.10和2.09,A260/A230依次为2.01、1.98和1.94。实际抽提效果会因实验条件、检测仪器等的不同而存在差异,本图仅供参考。
4. 使用快速便捷!
采用柱纯化法,无需繁琐的RNA沉淀步骤,抽提操作过程仅15-25分钟。相比于传统的Trizol抽提法,RNAeasy™试剂盒的操作流程显著简化,缩短了抽提时间,降低了RNA被降解的风险。和国外同类柱纯化产品相比,所需操作步骤和操作时间基本一致。RNAeasy™离心柱式长链RNA、小RNA和总RNA抽提试剂盒的抽提流程请参考如下的示意图(图4-6)。

图4. 离心柱式长链RNA抽提流程示意图

图5. 离心柱式小RNA抽提流程示意图

图6. 离心柱式总RNA抽提流程示意图
RNA抽提试剂盒的产品选购:
如果用于常规的非小RNA相关的用途,例如反转录、RT-PCR、qPCR、Northern、点杂交(Dot Blot)、纯化mRNA、体外翻译、RNase protection assay、cDNA克隆、基因表达芯片分析、高通量测序等,推荐选购碧云天的RNAeasy™动物长链RNA抽提试剂盒(离心柱式)(R0024、R0026和R0027),性价比最高。
碧云天的RNAeasy™动物长链RNA抽提试剂盒与Qiagen公司的RNeasy Mini Kit一致,用于纯化200nt以上的长链RNA,而小于200nt的small RNA即小RNA(如5.8S rRNA、5S rRNA、tRNA、miRNA、piRNA等)被选择性地去除。
如果希望抽提得到小于200nt的小RNA,推荐使用碧云天的RNAeasy™动物小RNA抽提试剂盒(离心柱式)(R0028)。该试剂盒与Thermo公司的PureLink™ miRNA Isolation Kit、Qiagen公司的miRNeasy Mini Kit为同类产品。
如果希望同时抽提获得长链RNA和小RNA,推荐选购RNAeasy™动物总RNA抽提试剂盒(离心柱式)(R0032)。该试剂盒国际上主要的试剂公司目前尚未见类似产品。
索取试用装:
请发送邮件至order@beyotime.com或致电碧云天(400-1683301或800-8283301)。每个实验室仅限赠送一个可以抽提12个样品的免费试用装!送完为止!
| 产品编号 | 产品名称 | 包装 |
| R0024FT | RNAeasy™动物长链RNA抽提试剂盒(离心柱式)(试用装) | 12次 |
附产品订购信息:
| 产品编号 | 产品名称 | 包装 | 产品价格 |
| R0024 | RNAeasy™动物长链RNA抽提试剂盒(离心柱式) | 12次 | 118.00元 |
| R0026 | RNAeasy™动物长链RNA抽提试剂盒(离心柱式) | 50次 | 398.00元 |
| R0027 | RNAeasy™动物长链RNA抽提试剂盒(离心柱式) | 200次 | 1358.00元 |
| R0028 | RNAeasy™动物小RNA抽提试剂盒(离心柱式) | 50次 | 598.00元 |
| R0032 | RNAeasy™动物总RNA抽提试剂盒(离心柱式) | 50次 | 498.00元 |
Ⅲ、
PCR惊喜,一波三叠!
超低价Taq、Pfu,高保真BeyoFusion!
Easy-Load™系列直接上样PCR预混液(提供免费试用)!
PCR惊喜,一波三叠!
似绕梁三日,又入木三分!
期勇冠三军,实三生有幸!
高品质、超低价Taq酶、Pfu酶:
高品质Taq酶低至不足0.04元/20μl反应,冲击地球最低价!
PCR鉴定、定量等的不二选择!
高保真Pfu酶,性能达国际同类产品,
价格仅0.06元/20μl反应!
PCR全面进入低价时代!
高保真、高性能、超低价BeyoFusion™、BeyoFusion™ Plus:
高保真PCR酶BeyoFusion™、BeyoFusion™ Plus,轻松扩增12kb片段(参考图1)!
保真性达到4.4×10-7/nt/cycle,比Pfu高6倍,与国际同类产品持平!
BeyoFusion™ Plus更超越同类产品,PCR产物能直接用于T载体克隆!
仅国外同类产品10%的价格!
基因克隆、测序扩增等高保真扩增的优先选择!
 图1. BeyoFusion™ DNA polymerase以λDNA为模板,PCR扩增不同长度(0.5-12kb)片段的电泳图。
图1. BeyoFusion™ DNA polymerase以λDNA为模板,PCR扩增不同长度(0.5-12kb)片段的电泳图。
懒人最爱、超低价Easy-Load™ PCR Master Mix系列:
真正的All in One PCR预混液!
从PCR到上样一步到位,Easy-Load™ PCR Master Mix系列全新上市!
连上样缓冲液都不用单独加了!
酶、dNTP、PCR反应缓冲液、上样缓冲液全部预混和!
仅需模板和基因特异性的引物就够了!
更能耐受反复冻融,实测反复冻融15次后,效果完全一致(参考图2)!
提供免费试用,赶快申领!
 图2. 本产品反复冻融15次前后扩增不同长度产物的效果图。A. 反复冻融前本产品进行PCR的扩增结果。B. 反复冻融15次后的本产品进行PCR的扩增结果。除本产品是否反复冻融15次外,A和B的反应体系完全相同,电泳的上样量也相同。
图2. 本产品反复冻融15次前后扩增不同长度产物的效果图。A. 反复冻融前本产品进行PCR的扩增结果。B. 反复冻融15次后的本产品进行PCR的扩增结果。除本产品是否反复冻融15次外,A和B的反应体系完全相同,电泳的上样量也相同。
免费试用装信息:
| 产品编号 | 产品名称 | 包装 |
| D7251FT | Easy-Load™ PCR Master Mix (Blue, 2X)(试用装) | 20次 |
附产品订购信息:
Ⅳ、
连接新时代,DNA连接产品全线特价,3.2折起!
冲击T4 DNA Ligase价格底线!仅0.88元/kU!
5分钟快速连接试剂盒!1.33元/次起!
连接新时代!连接生命科学的新时代!
DNA连接产品全线特价,3.2折起! 科研要有底线!价格不需要底线!
T4 DNA Ligase价格再次冲击底线!低至0.88元/kU! 连接反应不再需要漫漫长夜!
不再需要16度水浴锅!
室温5分钟搞定连接反应!
实测快速连接10分钟达到连接过夜70%以上克隆数目。
实测快速连接30分钟达到连接过夜基本相同的克隆数目。 图1.快速DNA连接试剂盒实测效果图。双酶切后的载体室温自连30min(A)或16℃自连过夜(D)作为阴性对照;双酶切后的载体与待插入片段室温连接10min(B)、30min(C)或者16℃连接过夜(E),随后转化细菌涂板,并于第二天取平板观察拍照。 震撼低价!每次快速连接仅1.33元!
图1.快速DNA连接试剂盒实测效果图。双酶切后的载体室温自连30min(A)或16℃自连过夜(D)作为阴性对照;双酶切后的载体与待插入片段室温连接10min(B)、30min(C)或者16℃连接过夜(E),随后转化细菌涂板,并于第二天取平板观察拍照。 震撼低价!每次快速连接仅1.33元!
DNA连接技术,还有哪家强? 碧云天产品,>28888篇文献的选择!
你的连接,你的论文,你的选择?!
| 产品编号 | 产品名称 | 产品包装 | 产品价格 | 特价 | 折扣 |
| D7002 | 快速DNA连接试剂盒 | 100次 | 268.00元 | 168.00元 | 6.3折 |
| D7003 | 快速DNA连接试剂盒 | 500次 | 898.00元 | 666.00元 | 7.4折 |
| D7006 | T4 DNA Ligase | 40,000U | 138.00元 | 48.00元 | 7.4折 |
| D7008 | T4 DNA Ligase | 200,000U | 552.00元 | 176.00元 | 3.2折 |
Ⅴ、
| 全新反转录酶重磅出击! |
||||||||||||||||||||||||
| 反转录酶哪家强? |
||||||||||||||||||||||||
| 价格(冲击全球最低价): 反转录酶价格比较:
注2:部分公司反转录酶价格较低时提供的是含RNase H活性的反转录酶,而碧云天提供的是高质量的不含RNase H活性的反转录酶。 |
||||||||||||||||||||||||
整套反转录试剂价格比较(包含引物、dNTP和RNase inhibitor和DPEC水等的价格):
注2:部分公司反转录酶价格较低时提供的是含RNase H活性的反转录酶,而碧云天提供的是高质量的不含RNaseH活性的反转录酶。 注3:有些公司的整套反转录试剂价格出现低于反转录酶的价格,是由于使用的是不同价格的不同反转录酶导致的。 |
||||||||||||||||||||||||
| 价格这么低!这是为什么嗫? 1. 碧云天研发出了非常高效的BeyoRT™ II M-MLV反转录酶(RNase H-)的表达系统,使产量大大提高,并且采 用的是碧云天自行研发的 蛋白纯化系统,从而大大降低了生产成本! 2. 薄利多销!薄利多销!薄利多销!重要的事情说三遍! |
||||||||||||||||||||||||
| 质量(三大优势): 1. 反转录的最大长度可以超过10 kb (参考图1)! 2. 真正的RNase H缺失的反转录酶,确保超高反转录效率,大大提高反转录产物得率! 3. 精细点突变,提升反转录酶的热稳定性,温度达到50℃时仍具有很高活性(参考图2)!  图1. 使用BeyoRT™ II M-MLV反转录酶(RNase H-)反转录总RNA后,对于不同长度的cDNA进行PCR扩增后的电泳效果图。图中可见对于0.2-8kb的cDNA可以非常高效地被反转录。  图2. BeyoRT™ II M-MLV反转录酶(RNase H-)在不同温度下的反转录效果。用从NIH3T3细胞抽提获得的总RNA 500 ng,在20μl的反转录体系中按照图中所示温度进行反转录。反转录完成后取1μl反转录产品进行目的基因的PCR扩增和电泳。 |
||||||||||||||||||||||||
| 免费试用装(2000U,足够10次反转录反应),大派送!每个实验室仅限提供一个试用装!送完为止! | ||||||||||||||||||||||||
| 标题图片说明:该照片拍摄自2010年上海世博会意大利馆,图片中可见动物图案的意大利面。 | ||||||||||||||||||||||||
| 附产品订购信息: | ||||||||||||||||||||||||
|
Ⅵ、
| Lipo6000™转染试剂 |
||||||||||||||||
| 还在为昂贵的细胞转染试剂在寒冬中煎熬? |
||||||||||||||||
|
||||||||||||||||
|
||||||||||||||||
|
||||||||||||||||
|
||||||||||||||||
|
||||||||||||||||
|
||||||||||||||||
附产品订购信息: |
||||||||||||||||
|












